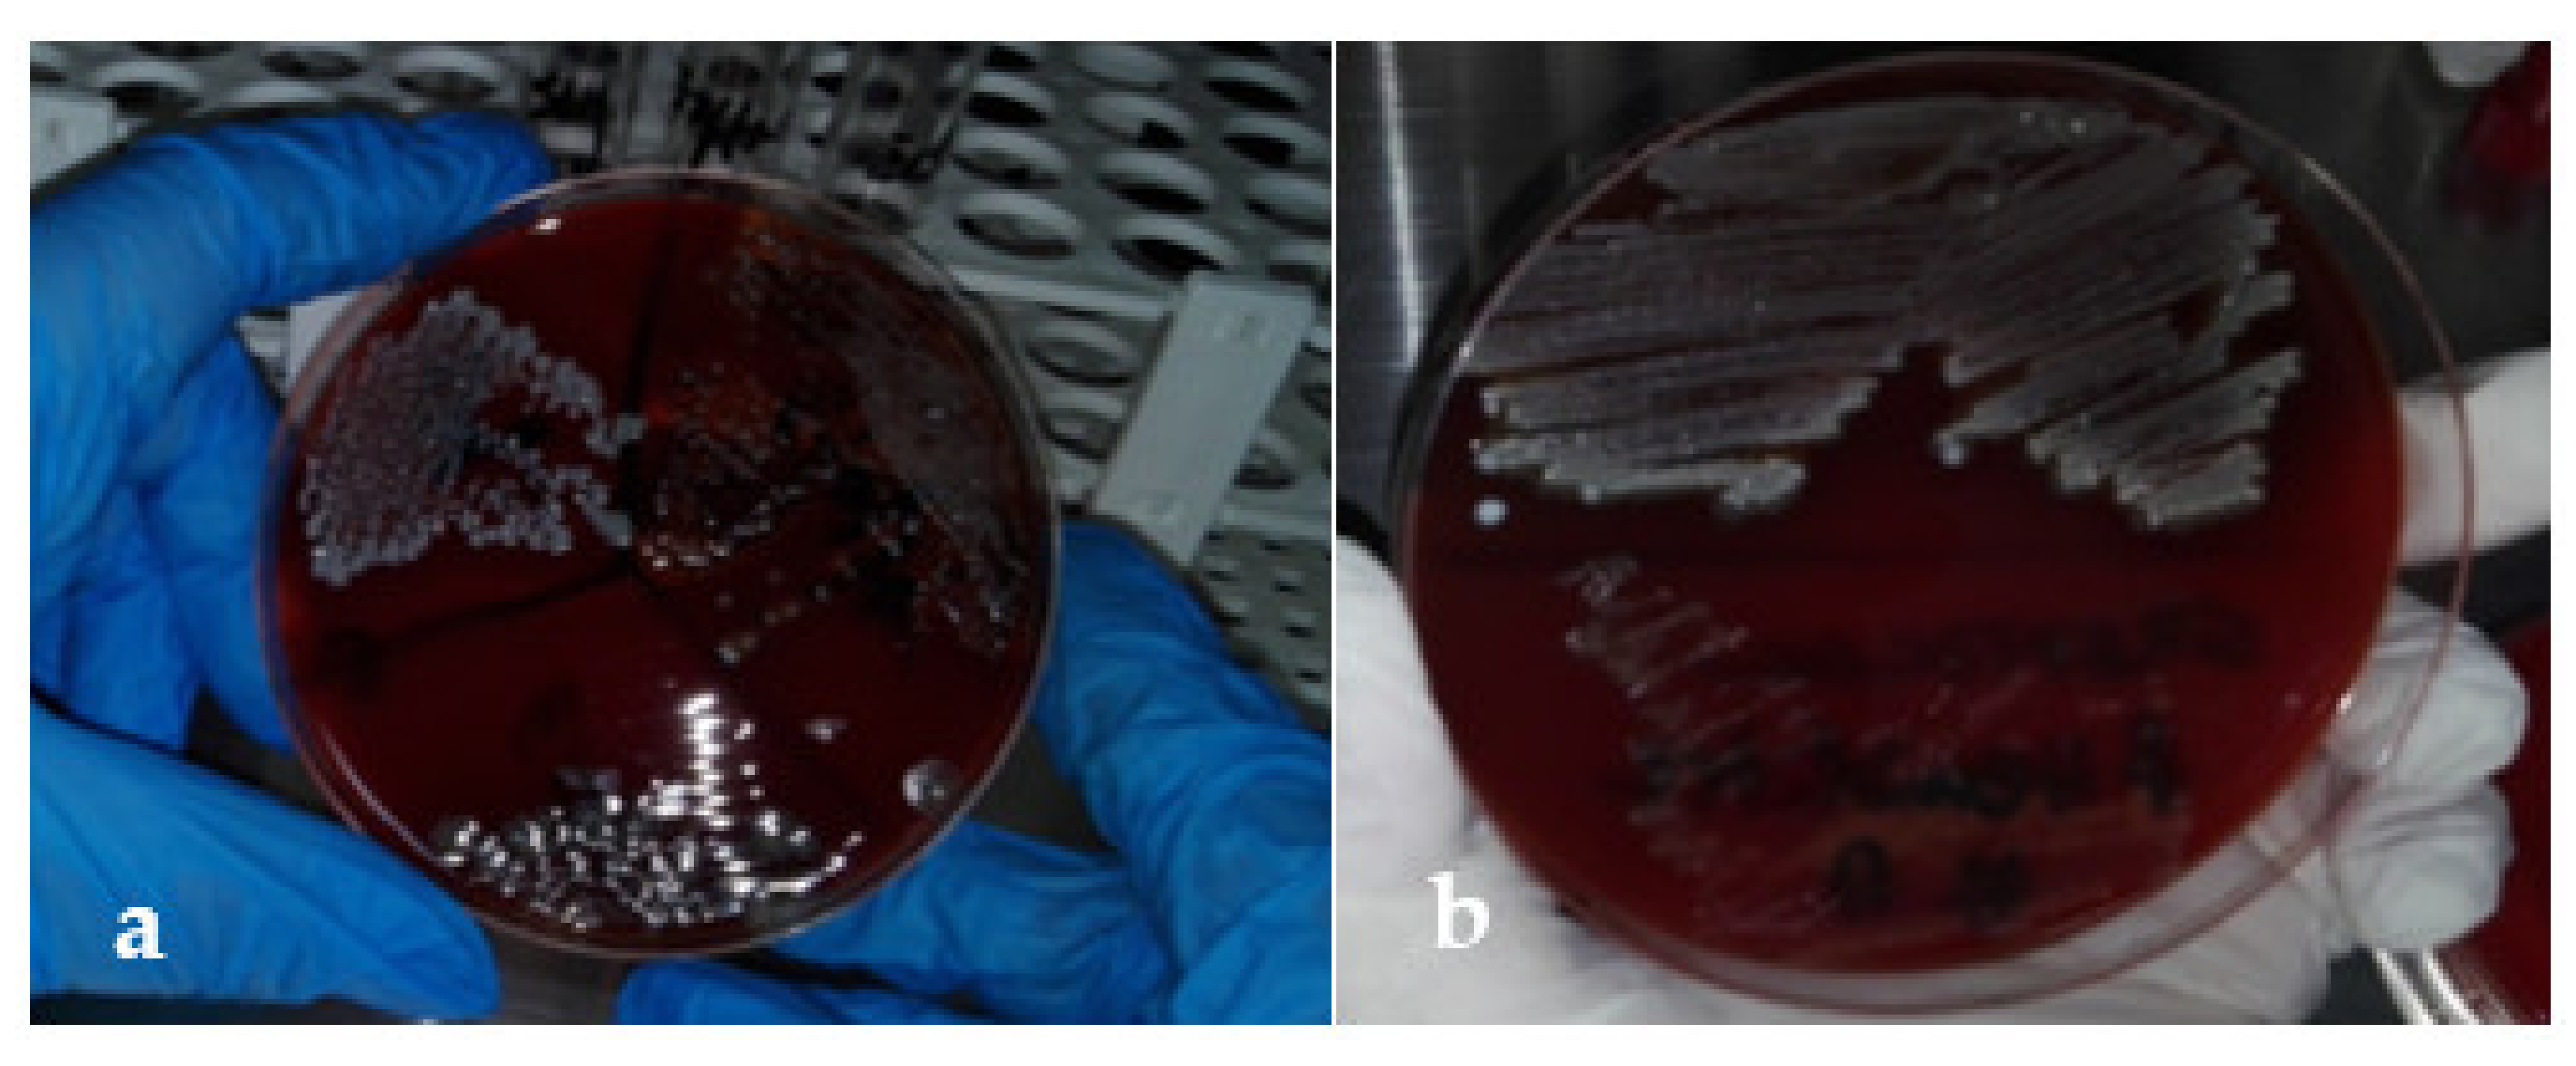
Applsci 12 02751 g001 Applsci 12 02751 g001
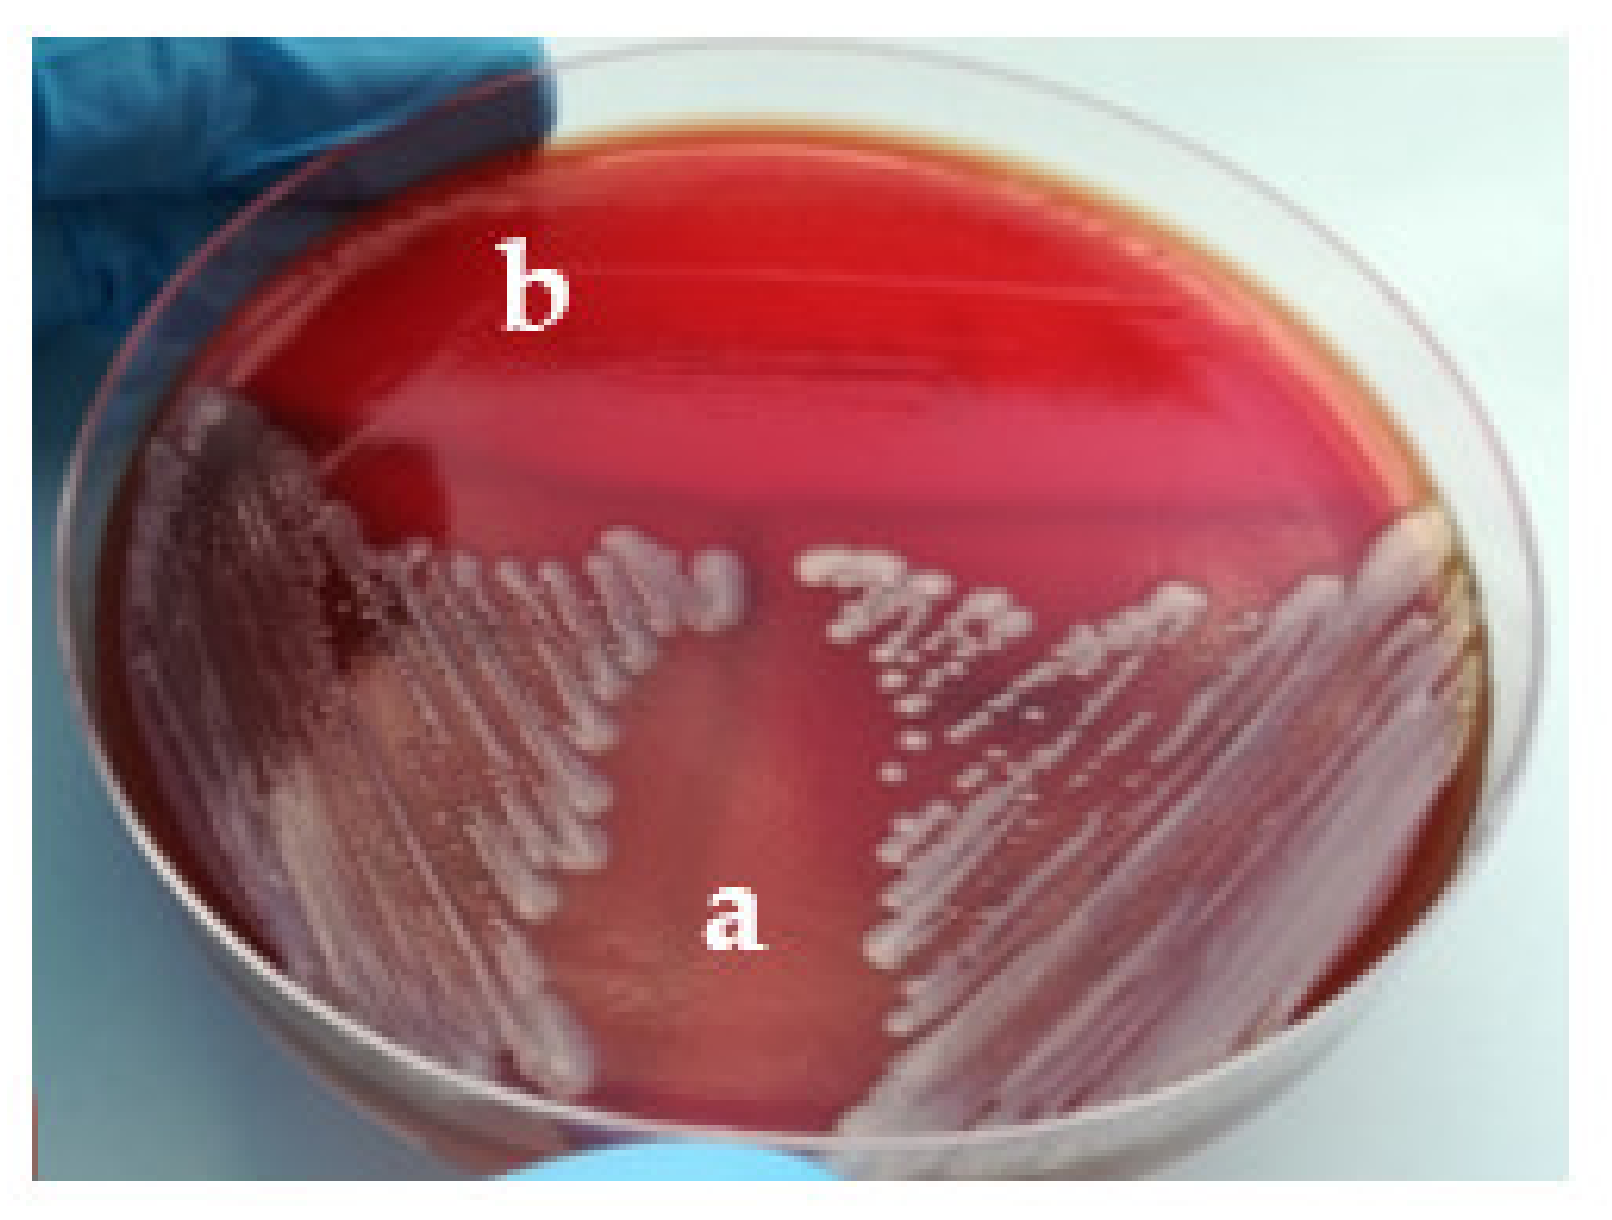
Applsci 12 02751 g003 Applsci 12 02751 g003
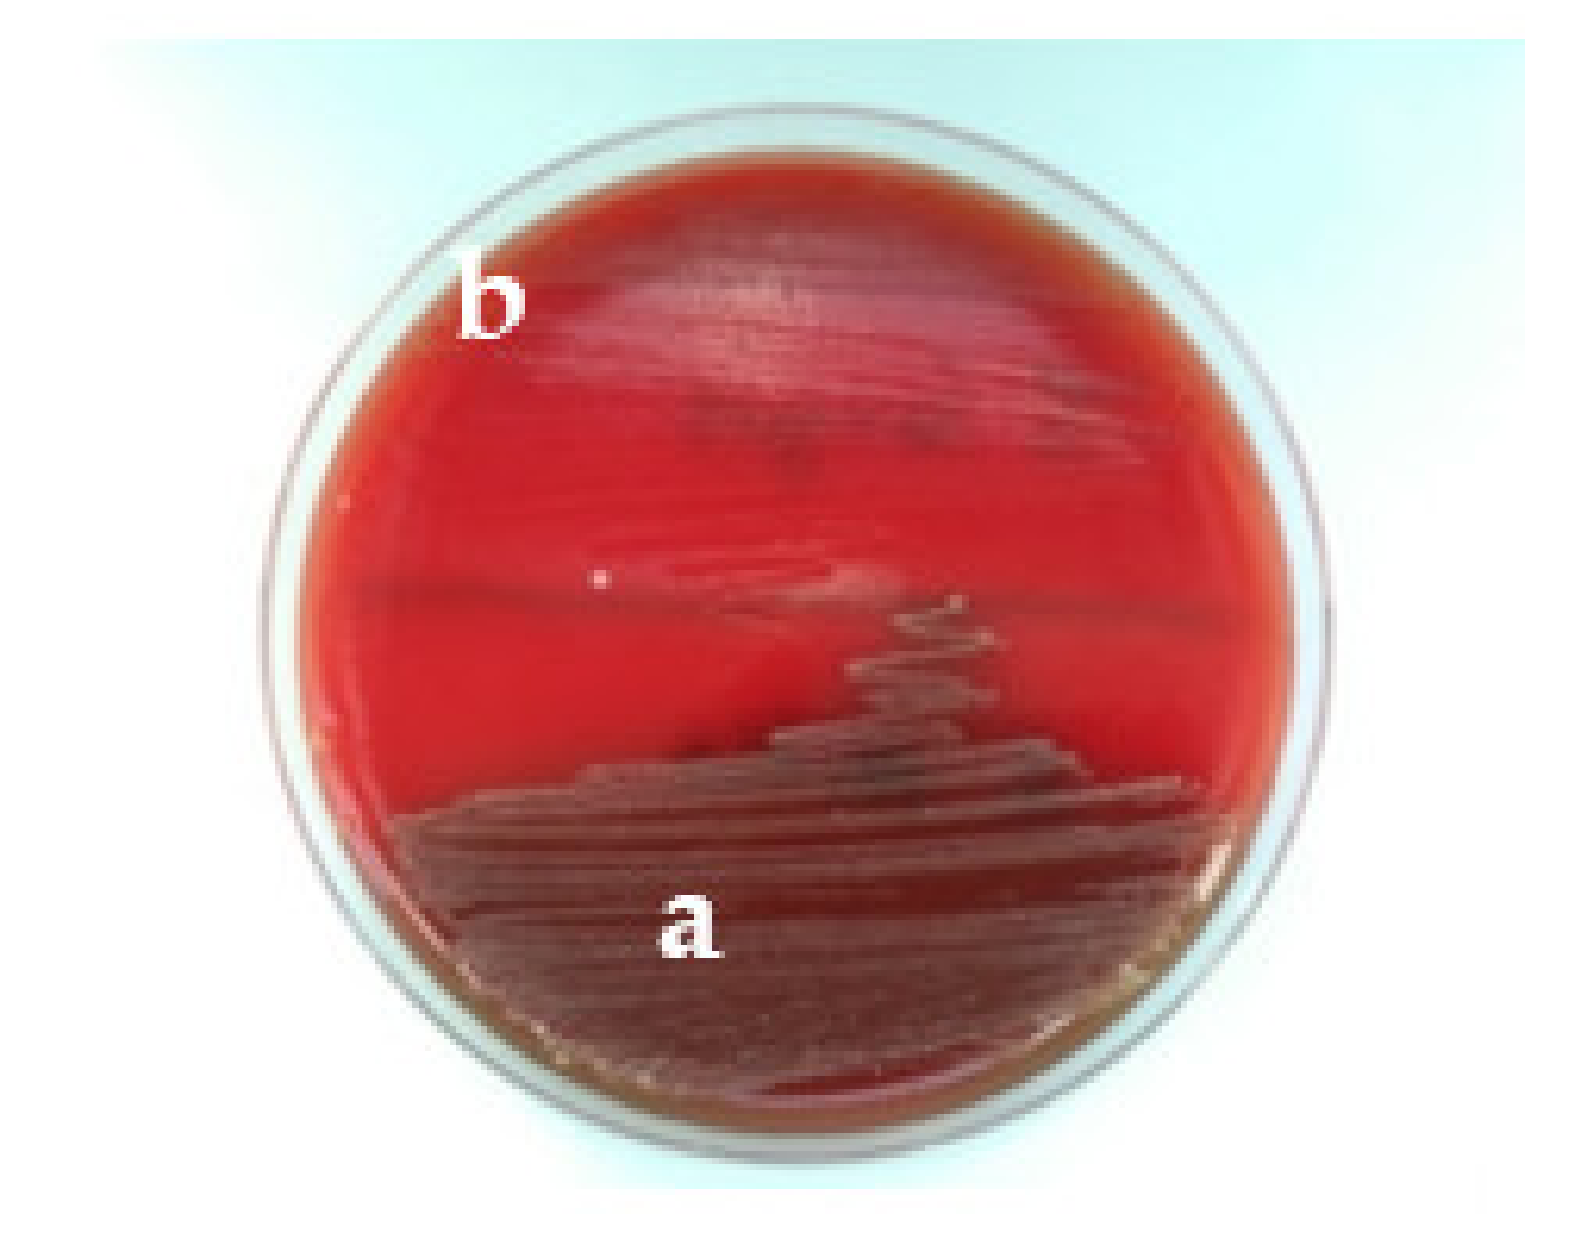
Applsci 12 02751 g004 Applsci 12 02751 g004
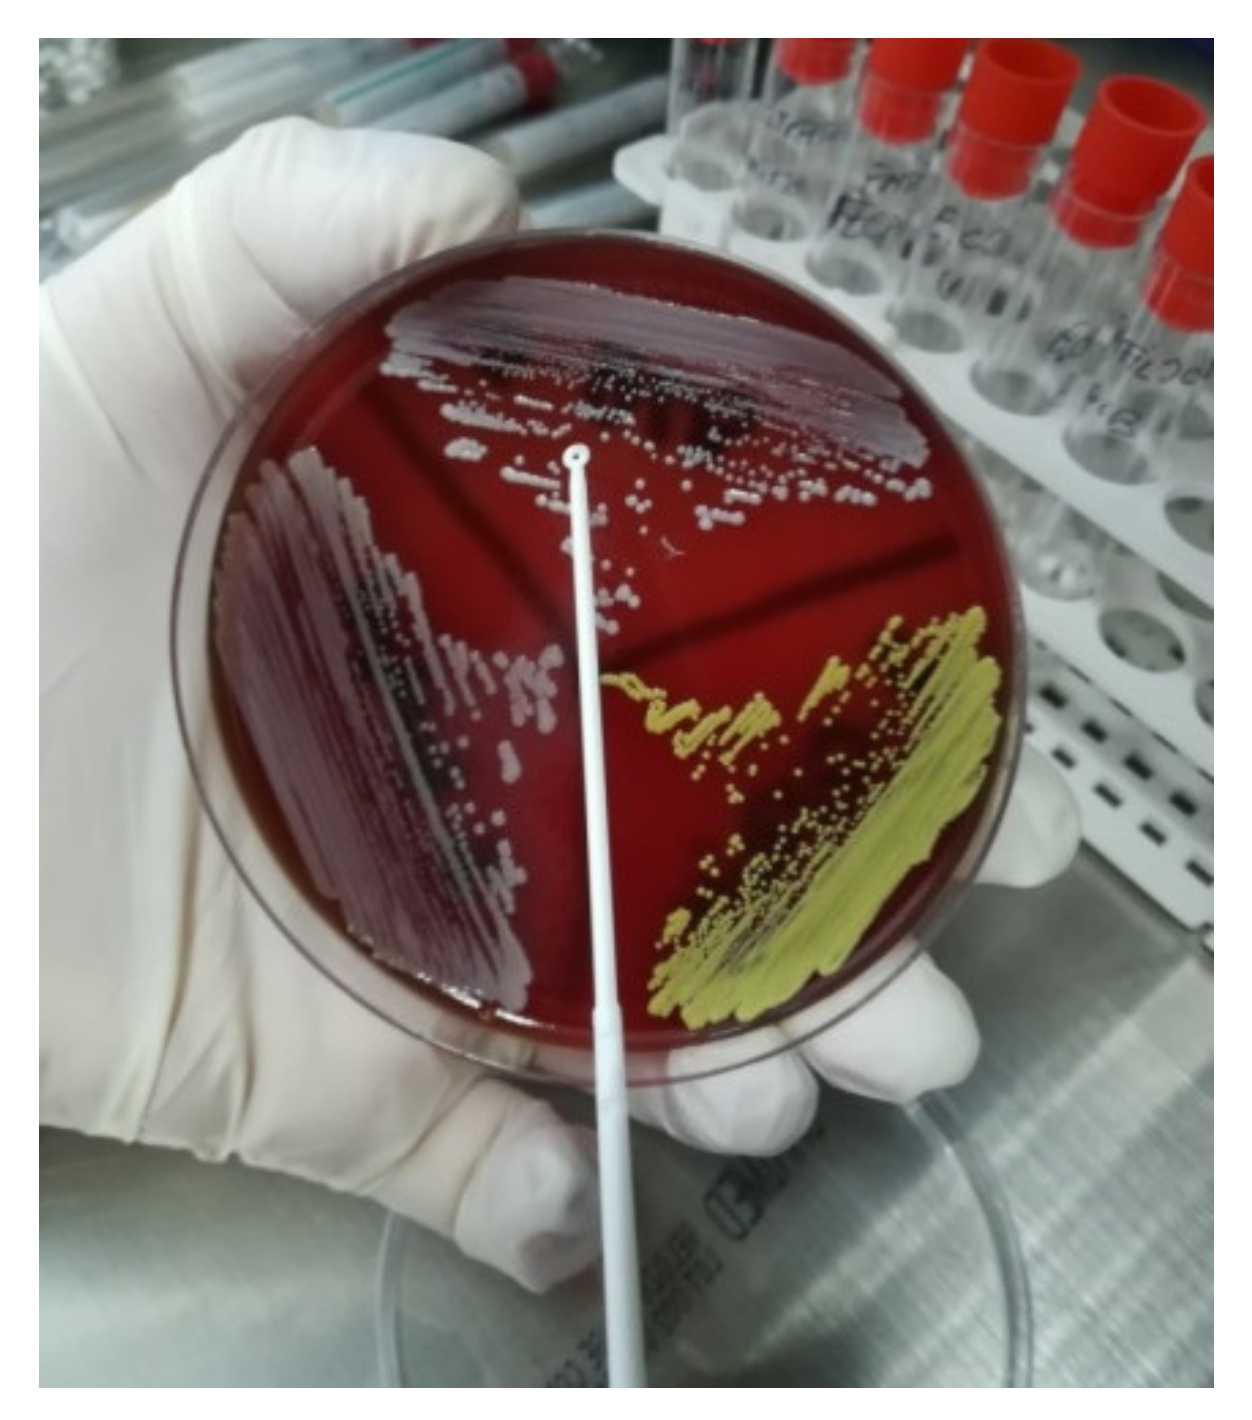
Applsci 12 02751 g005 Applsci 12 02751 g005
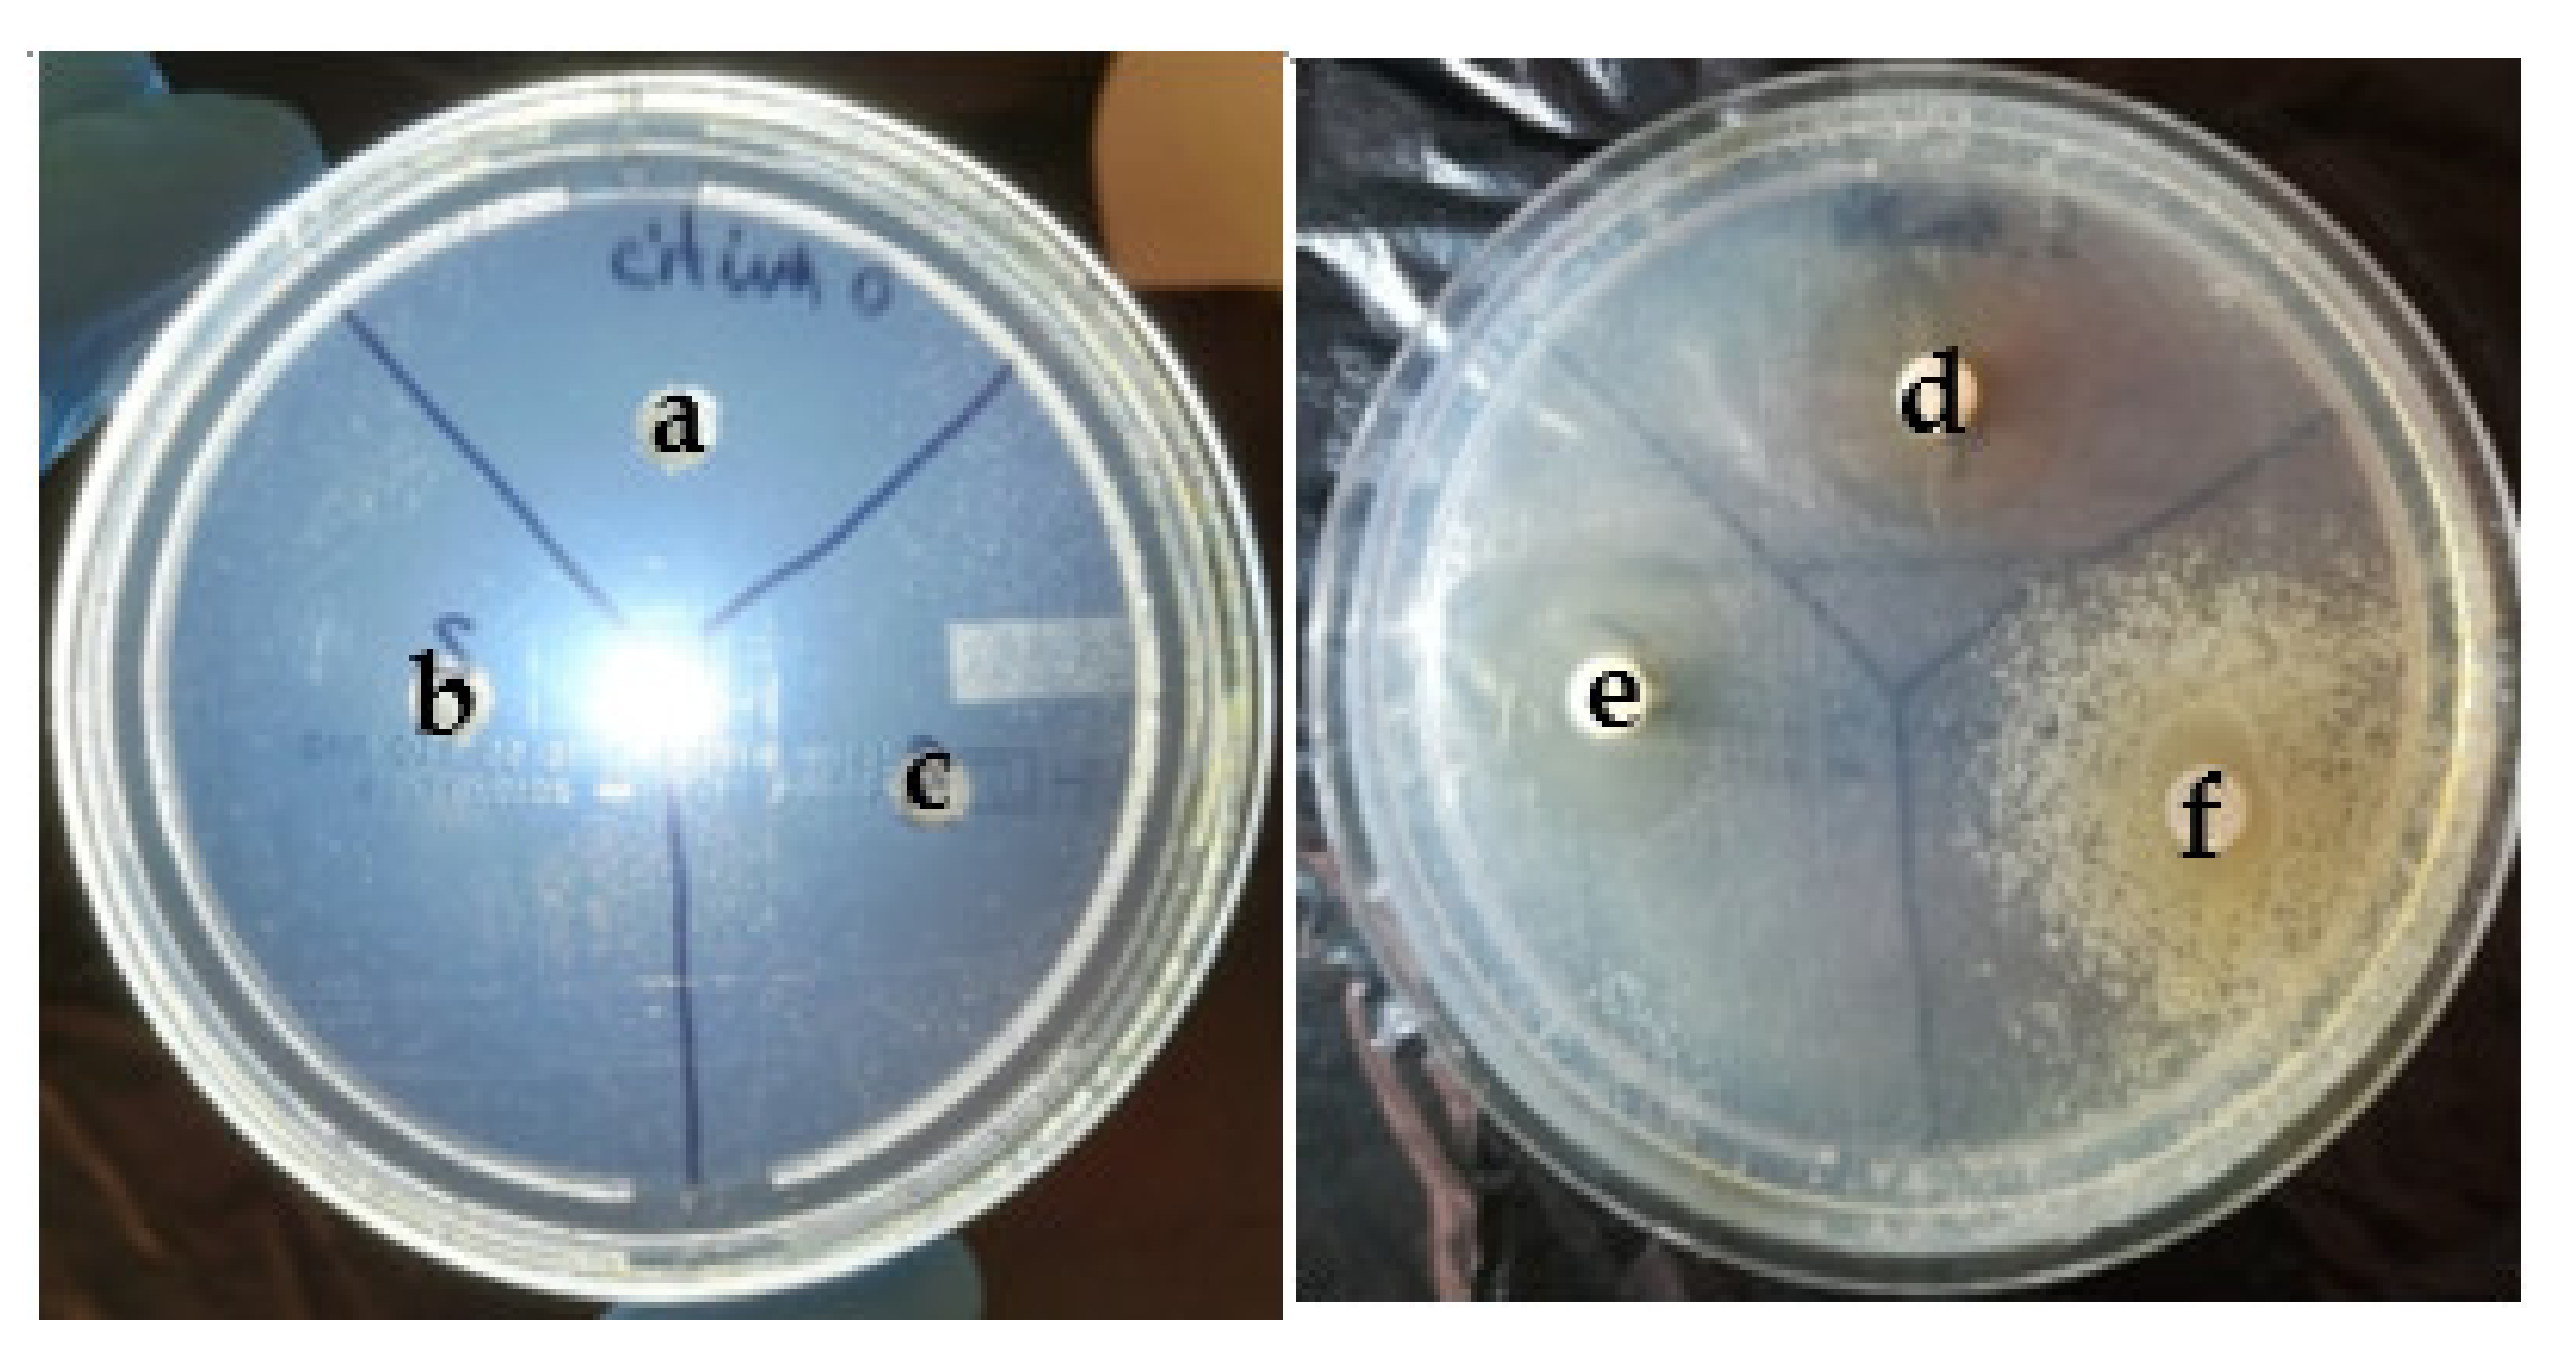
Applsci 12 02751 g010 Applsci 12 02751 g010
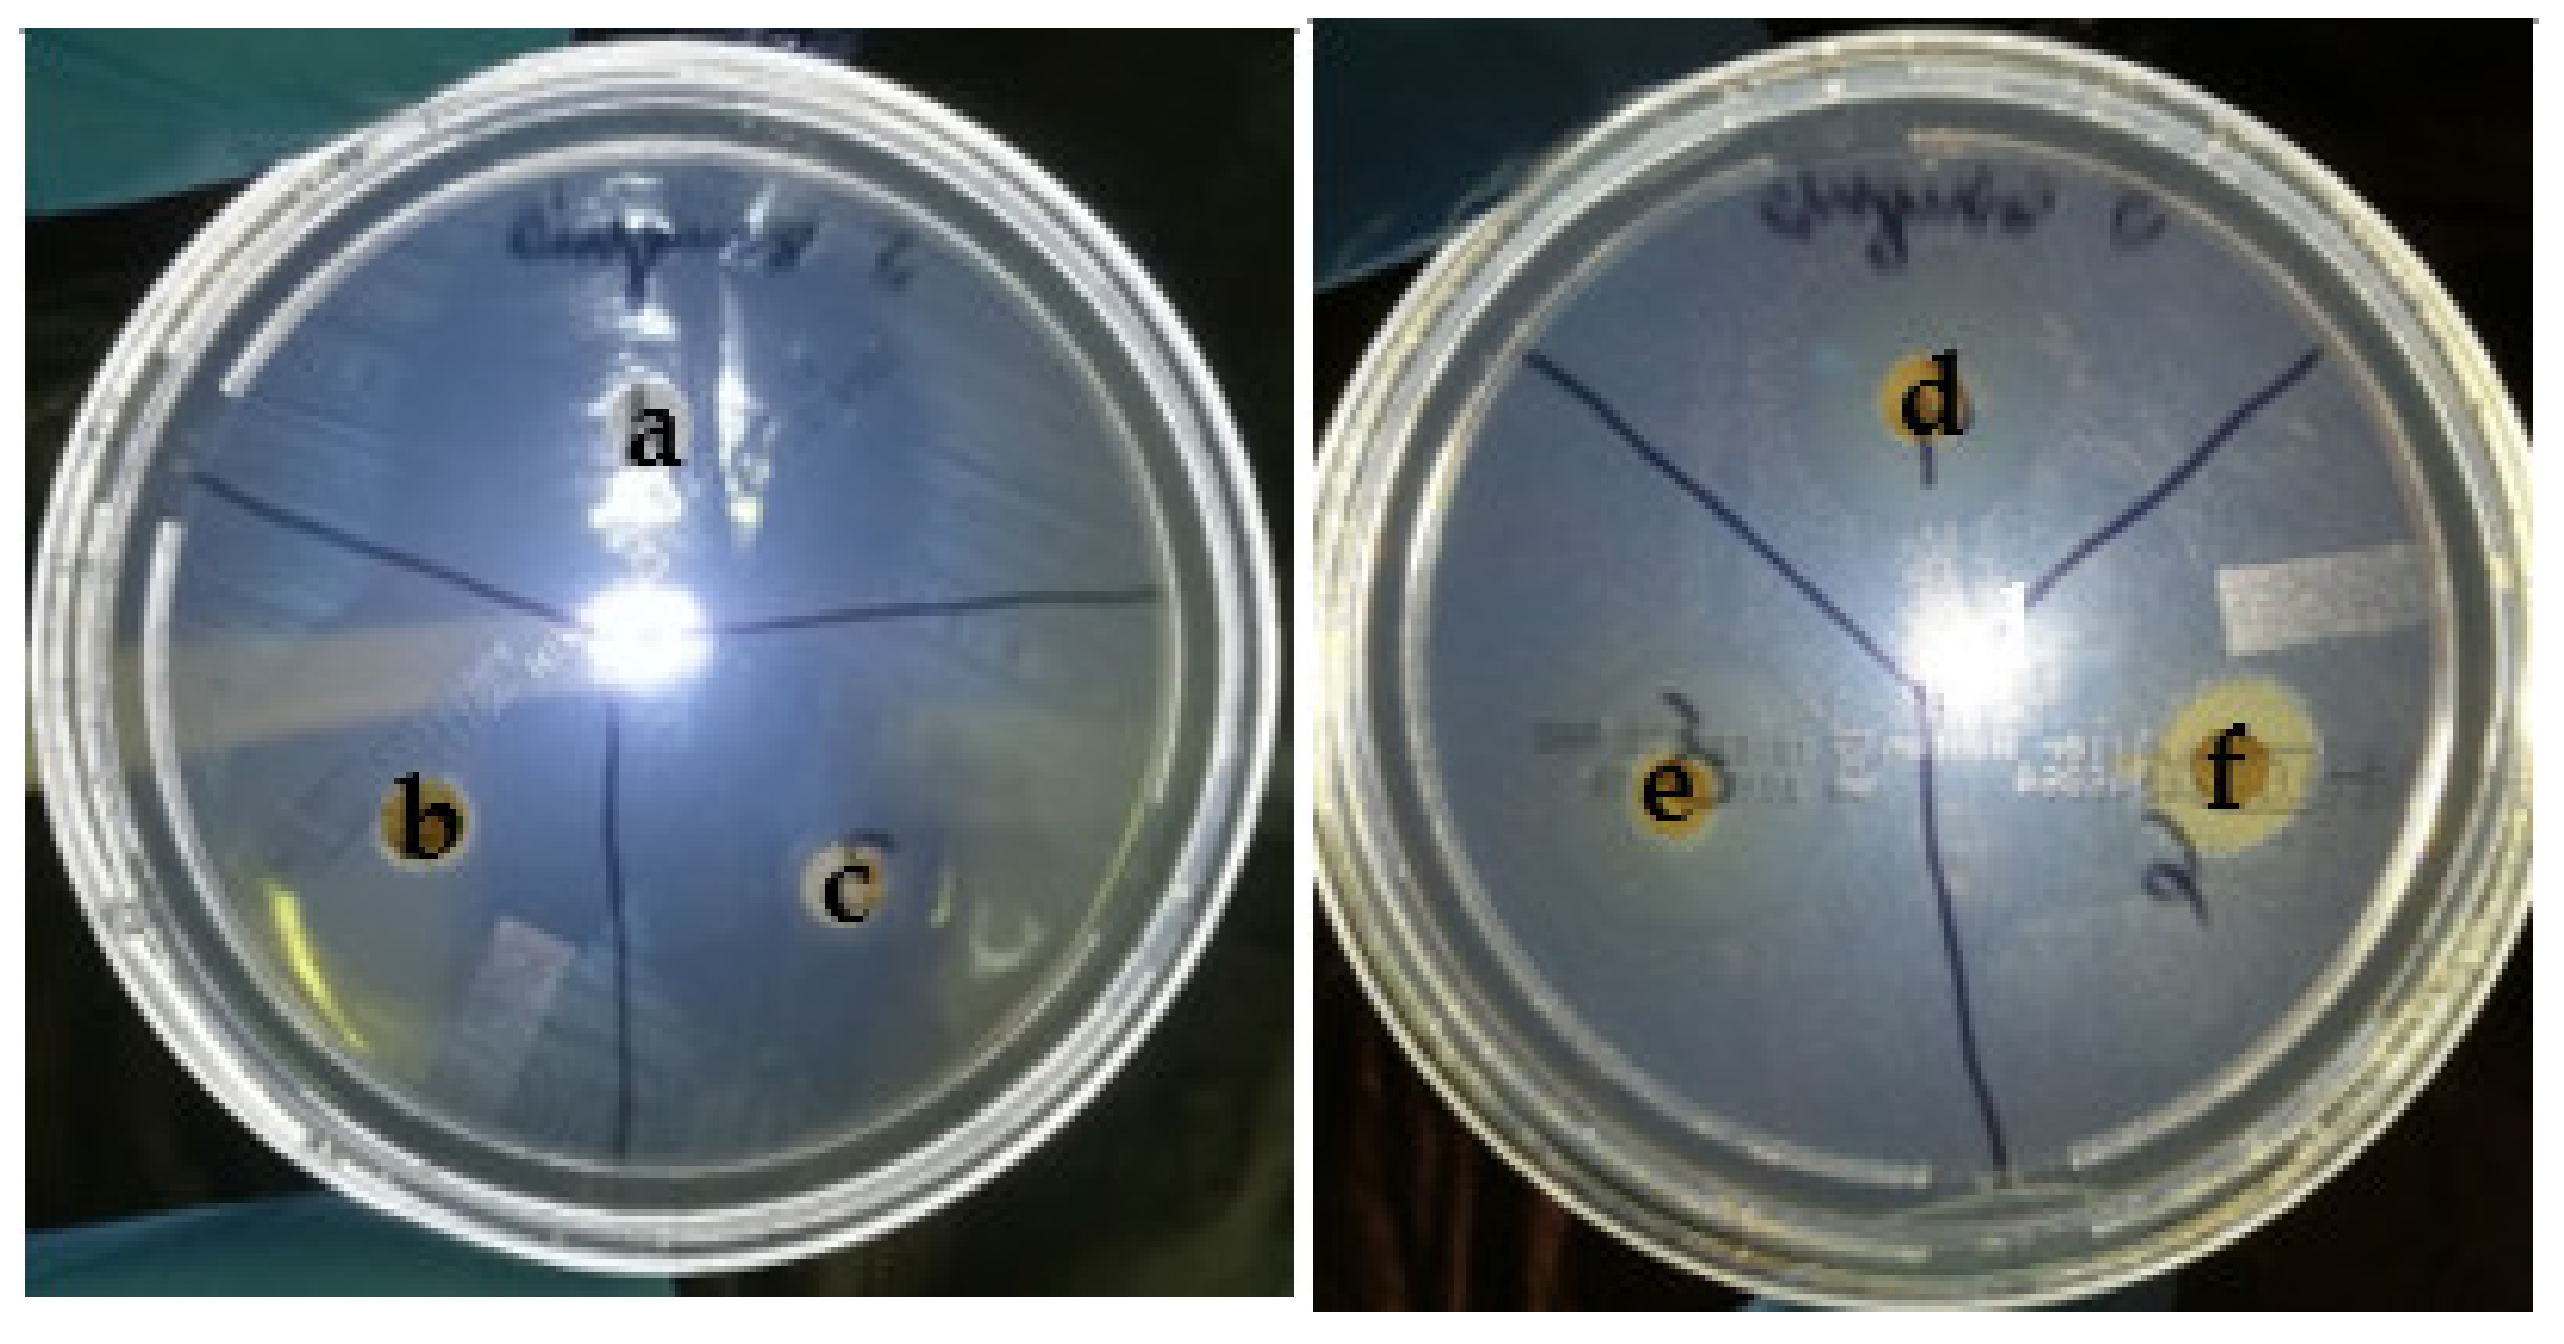
Applsci 12 02751 g011 Applsci 12 02751 g011
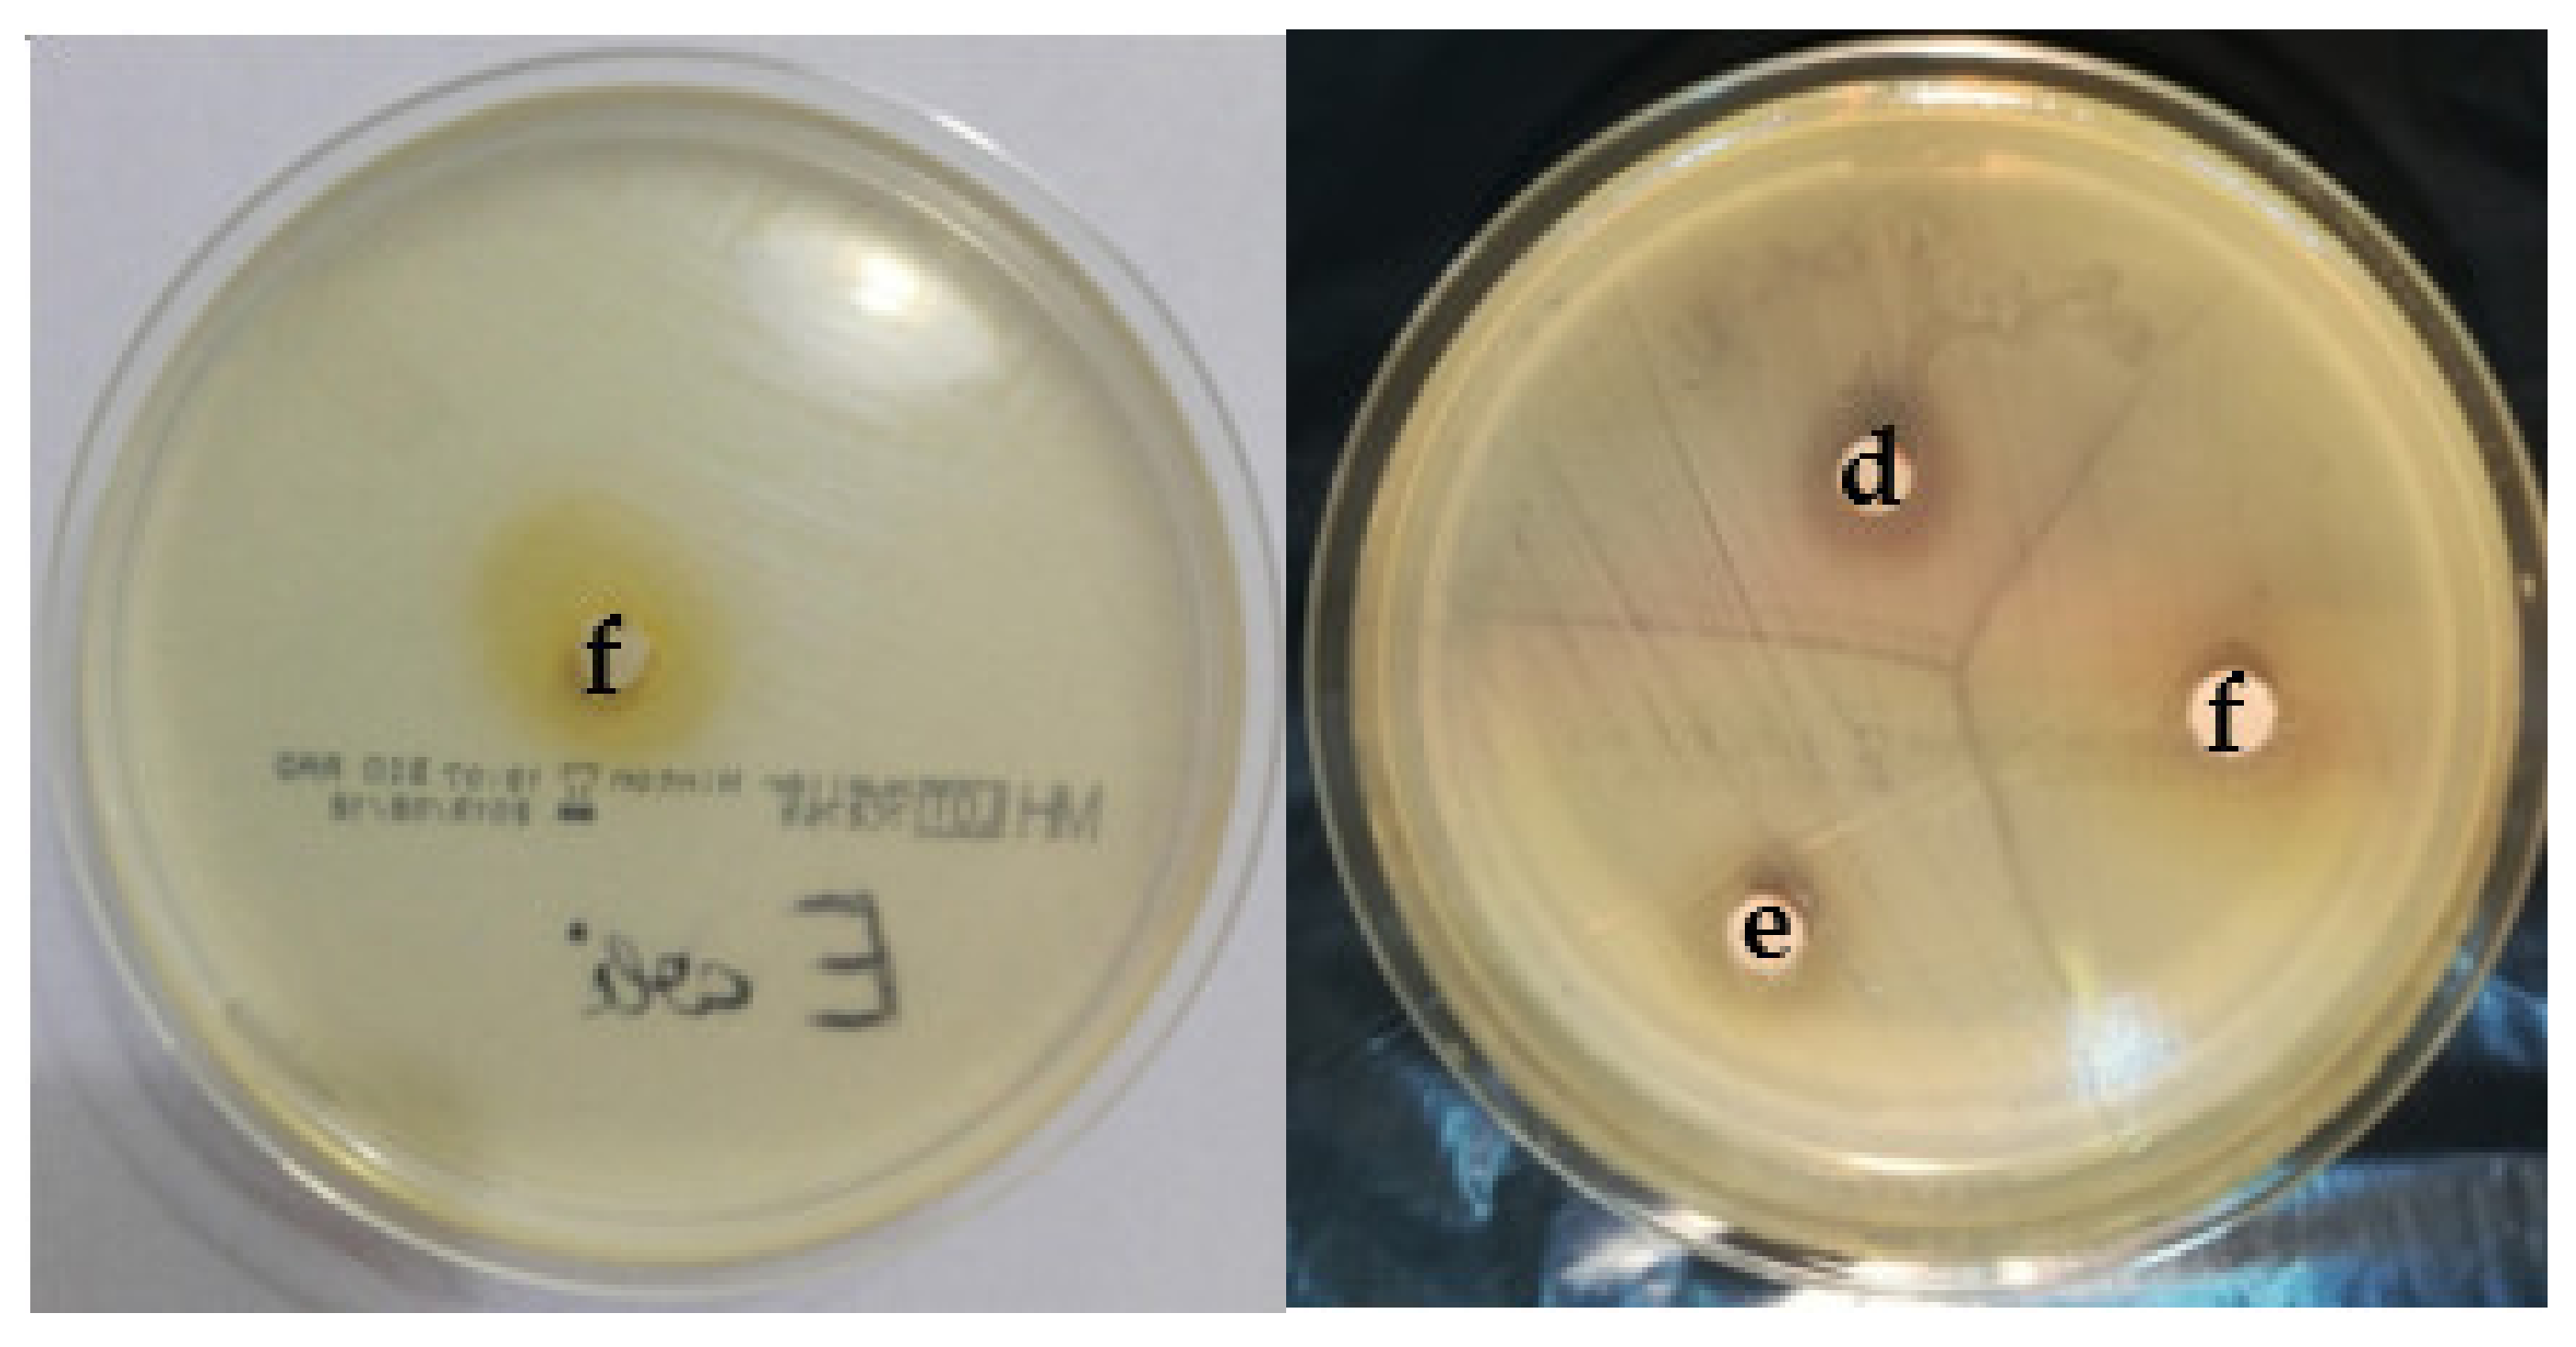
Applsci 12 02751 g012 Applsci 12 02751 g012

Studies Regarding the Antibacterial Effect of Plant Extracts Obtained from Epilobium parviflorum Schreb
Abstract
1. Introduction
- (1)
- Identification and quantification of phenols and flavonoids from the vegetable extracts obtained from Epilobium parviflorum Schreb.;
- (2)
- Testing the antibacterial activity of the vegetable extracts.
2. Materials and Methods
2.1. Harvesting the Plant and Obtaining the Extracts
2.2. Identification and Quantification of Biologically Active Compounds
2.3. Bacteriological Tests
- Study group
- Harvesting pathological products
- Bacteriological identification technique
- Antibacterial effect testing technique of the vegetable extracts
2.4. Statistical Analysis
3. Results
3.1. Quantification of Total polyphenols in the Three Types of Plant Extracts
3.2. Quantification of Total Flavonoids
3.3. Test Results for Antibacterial Activity of Plant Extracts
3.4. Correlations between Biologically Active Compounds and the Antibacterial Effect
3.5. Antibacterial Effect of Experimental vs. Commercial Irrigants
4. Discussion
5. Conclusions
Author Contributions
Funding
Institutional Review Board Statement
Informed Consent Statement
Conflicts of Interest
References
- Vitalone, A.; Allkanjari, O. Epilobium spp: Pharmacology and phychemistry. Phytother. Res. 2018, 32, 1229–1240. [Google Scholar] [CrossRef] [PubMed]
- Gafner, S. Herbal Drugs and Phytopharmaceuticals: A Handbook for Practice on a Scientific Basis. J. Nat. Prod. 2004, 67, 1774–1775. [Google Scholar] [CrossRef]
- Heves, B.T.; Houghton, P.J.; Habtemariam, S.; Kéry, A. Antioxidant and antiinflammatory effect of Epilobium parviflorum Schreb. Phytother Res. 2009, 23, 719–724. [Google Scholar] [CrossRef] [PubMed]
- Kim, J.H.; Park, K.M.; Lee, J.A. Herbal medicine for benign prostatic hyperplasia: A protocol for a systematic review of controlled trials. Medicine 2019, 98, e14023. [Google Scholar] [CrossRef]
- Kodeš, Z.; Vrublevskaya, M.; Kulišová, M.; Jaroš, P.; Paldrychová, M.; Pádrová, K.; Lokočová, K.; Palyzová, A.; Maťátková, O.; Kolouchová, I. Composition and Biological Activity of Vitis vinifera Winter Cane Extract on Candida Biofilm. Microorganisms 2021, 9, 2391. [Google Scholar] [CrossRef]
- Tsao, R. Chemistry and Biochemistry of Dietary Polyphenols. Nutrients 2010, 2, 1231–1246. [Google Scholar] [CrossRef]
- Squillaci, G.; Giorio, L.A.; Cacciola, N.A.; La Cara, F.; Morana, A. Effect of temperature and time on the phenolic extraction from grape canes. In Wastes-Solutions, Treatments and Opportunities, Wastes III; Routledge: London, UK, 2019. [Google Scholar]
- Nagy-Bota, M.C.; Man, A.; Santacroce, L.; Brinzaniuc, K.; Pap, Z.; Pacurar, M.; Pribac, M.; Ciurea, C.N.; Pintea-Simon, I.A.; Kovacs, M. Essential Oils as Alternatives for Root-Canal Treatment and Infection Control against Enterococcus faecalis—A Preliminary Study. Appl. Sci. 2021, 11, 1422. [Google Scholar] [CrossRef]
- Lee, D.; Im, J.; Na, H.; Ryu, S.; Yun, C.-H.; Han, S.H. The Novel Enterococcus Phage VB_EfaS_HEf13 Has Broad Lytic Activity against Clinical Isolates of Enterococcus faecalis. Front. Microbiol. 2019, 10, 2877. [Google Scholar] [CrossRef]
- Alghamdi, F.; Shakir, M. The Influence of Enterococcus faecalis as a Dental Root Canal Pathogen on Endodontic Treat-ment: A Systematic Review. Cureus 2020, 12, e7257. [Google Scholar]
- Amaral, R.R.; Oliveira, A.G.G.; Braga, T.; Reher, P.; de Macedo Farias, L.; Magalhães, P.P.; Ferreira, P.G.; de Souza Côrtes, M.I. Quantitative Assessment of the Efficacy of Two Different Single-File Systems in Reducing the Bacterial Load in Oval-Shaped Canals: A Clinical Study. J. Endod. 2020, 46, 1228–1234. [Google Scholar] [CrossRef]
- Pușcașu, C.G.; Caraiane, A.; Dumea, E.; Șachir, E.E.; Raftu, G.; Pușcașu, R.A.; Bartok-Nicolae, C.; Cernei, E.R.; Sachelarie, L.; Hurjui, L.L. Measurement of the Clinical Effects of a Marine Fish Extract on Periodontal Healing—A Preliminary Clinical Interventional Study. Appl. Sci. 2022, 12, 677. [Google Scholar] [CrossRef]
- Parolia, A.; Kumar, H.; Ramamurthy, S.; Madheswaran, T.; Davamani, F.; Pichika, M.R.; Mak, K.-K.; Fawzy, A.S.; Daood, U.; Pau, A. Effect of Propolis Nanoparticles against Enterococcus faecalis Biofilm in the Root Canal. Molecules 2021, 26, 715. [Google Scholar] [CrossRef] [PubMed]
- Song, W.; Ge, S. Application of Antimicrobial Nanoparticles in Dentistry. Molecules 2019, 24, 1033. [Google Scholar] [CrossRef] [PubMed]
- Singh, M.; Singh, S.; Salgar, A.R.; Prathibha, N.; Chandrahari, N.; Swapna, L.A. An in vitro comparative evaluation of antimicrobial efficacy of propolis, Morindacitrifolia Juice, sodium hypochlorite and chlorhexidine on Enterococcus faecalis and Candida albicans. J. Contemp. Dent. Pract. 2019, 20, 40–45. [Google Scholar]
- Puşcaşu, C.G.; Ștefănescu, C.L.; Murineanu, R.M.; Grigorian, M.; Petcu, L.C.; Dumea, E.; Sachelarie, L.; Puşcaşu, R.A. Histological Aspects Regarding Dental Pulp of Diabetic Patients. Appl. Sci. 2021, 11, 9440. [Google Scholar] [CrossRef]
- Jamshidi-Kia, F.; Lorigooini, Z.; Amini-Khoei, H. Medicinal plants: Past history and future perspective. J. Herbmed. Pharmacol. 2018, 7, 1–7. [Google Scholar] [CrossRef]
- Jayaraj, A.J.; Uchimahali, J.; Gnanasundaram, T.; Thirumal, S. Evaluation of antimicrobial activity and phytochemicals analysis of whole plant extract of Vinca rosea. Evaluation 2019, 12, 132–136. [Google Scholar]
- Arguelles-Peña, K.; Olguín-Rojas, J.A.; Acosta-Osorio, A.A.; Carrera, C.; Barbero, G.F.; García-Alvarado, M.Á.; Rodríguez-Jimenes, G.d.C. An Evaluation of the Equilibrium Properties in Hexane and Ethanol Extractive Systems for Moringa oleifera Seeds and Fatty Acid Profiles of the Extracts. Separations 2021, 8, 217. [Google Scholar] [CrossRef]
- Darwish, W.S.; Khadr, A.E.S.; Kamel, M.A.E.N.; Abd Eldaim, M.A.; El Sayed, I.E.T.; Abdel-Bary, H.M.; Ullah, S.; Ghareeb, D.A. Phytochemical Characterization and Evaluation of Biological Activities of Egyptian Carob Pods (Ceratonia siliqua L.) Aqueous Extract: In Vitro Study. Plants 2021, 10, 2626. [Google Scholar] [CrossRef]
- Świątek, Ł.; Sieniawska, E.; Mahomoodally, M.F.; Sadeer, N.B.; Wojtanowski, K.K.; Rajtar, B.; Polz-Dacewicz, M.; Paksoy, M.Y.; Zengin, G. Phytochemical Profile and Biological Activities of the Extracts from Two Oenanthe Species (O. aquatica and O. silaifolia). Pharmaceuticals 2022, 15, 50. [Google Scholar] [CrossRef]
- Vilkhu, K.; Mawson, R.; Simons, L.; Bates, D. Applications and opportunities for ul-trasound assisted extraction in the food industry—A review. Innov. Food Sci. Emerg. Technol. 2008, 9, 161–169. [Google Scholar] [CrossRef]
- Vinatoru, M. An overview of the ultrasonically assisted extraction of bioactive principles from herbs. Ultrason. Sonochem. 2001, 8, 303–313. [Google Scholar] [CrossRef]
- Hromàdkovà, Z.; Ebringerovà, A. Ultrasonic extraction of plant materials–investigation of hemicellulose release from buckwheat hulls. Ultrason. Sonochem. 2003, 10, 127–133. [Google Scholar]
- EDQM. European Pharmacopoeia, 9th ed.; European Pharmacopoeia, Council of Europe, B.P. 907, F-67029; EDQM: Strasbourg, France, 2016. [Google Scholar]
- Shami, A.M.M.; Philip, K.; Muniady, S. Synergy of antibacterial and antioxidant activities from crude extracts and peptides of selected plant mixture. BMC Complementary Altern. Med. 2013, 13, 360. [Google Scholar] [CrossRef] [PubMed]
- El-Mahrouk, M.E.; Dewir, Y.H. Physico-Chemical Properties of Compost Based Waste-Recycling of Grape Fruit as Nursery Growing Medium. Am. J. Plant Sci. 2016, 7, 48–54. [Google Scholar] [CrossRef]
- Gabriel, A.; Joe, V.; Patrick, E.D. Folin-Ciocalteau Reagent for Polyphenolic Assay. IJFS 2014, 3, 147–156. [Google Scholar]
- Adamiak, K.; Kurzawa, M.; Sionkowska, A. Physicochemical Performance of Collagen Modified by Melissa officinalis Extract. Cosmetics 2021, 8, 95. [Google Scholar] [CrossRef]
- Gaire, U.; Thapa Shrestha, U.; Adhikari, S.; Adhikari, N.; Bastola, A.; Rijal, K.R.; Ghimire, P.; Banjara, M.R. Antibiotic Susceptibility, Biofilm Production, and Detection of mecA Gene among Staphylococcus aureus Isolates from Different Clinical Specimens. Diseases 2021, 9, 80. [Google Scholar] [CrossRef]
- Contreras-Alvarado, L.M.; Zavala-Vega, S.; Cruz-Córdova, A.; Reyes-Grajeda, J.P.; Escalona-Venegas, G.; Flores, V.; Alcázar-López, V.; Arellano-Galindo, J.; Hernández-Castro, R.; Castro-Escarpulli, G.; et al. Molecular Epidemiology of Multidrug-Resistant Uropathogenic Escherichia coli O25b Strains Associated with Complicated Urinary Tract Infection in Children. Microorganisms 2021, 9, 2299. [Google Scholar] [CrossRef]
- Buiuc, D.; Neguţ, M. Tratat de Microbiologieclinică, 3rd ed.; EdituraMedicală: Bucharest, Romania, 2017. [Google Scholar]
- Remmel, I.; Lauri, V.; Lauri, T.; Vallo, M.; Ain, R. Phenolic Compounds in Five Epilobium Species Collected from Estonia. Nat. Prod. Commun. 2012, 7, 1323–1324. [Google Scholar] [CrossRef]
- Merighi, S.; Travagli, A.; Tedeschi, P.; Marchetti, N.; Gessi, S. Antioxidant and Antiinflammatory Effects of Epilobium parviflorum, Melilotus officinalis and Cardiospermum halicacabum Plant Extracts in Macrophage and Microglial Cells. Cells 2021, 10, 2691. [Google Scholar] [CrossRef] [PubMed]
- Bajer, T.; Šilha, D.; Karel, V.; Bajerová, P. Composition and antimicrobial activity of the essential oil, distilled aromatic water and herbal infusion from Epilobium parviflorum Schreb. Ind. Crops Prod. 2017, 100, 95–105. [Google Scholar] [CrossRef]
- Li, Y.; Liu, Y.; Yao, B.; Narasimalu, S.; Dong, Z. Rapid preparation and antimicrobial activity of polyurea coatings with RE-Doped nano-ZnO. Microb. Biotechnol. 2022, 15, 548–560. [Google Scholar] [CrossRef] [PubMed]
- Imani, S.M.; Ladouceur, L.; Marshall, T.; Maclachlan, R.; Soleymani, L.; Didar, T.F. Antimicrobial Nanomaterials and Coatings: Current Mechanisms and Future Perspectives to Control the Spread of Viruses Including SARS-CoV-2ACS. Nano 2020, 14, 12341–12369. [Google Scholar] [CrossRef] [PubMed]

| Concentration mg/mL | Absorbance at 760 nm |
|---|---|
| 5.00 | 3.6022 |
| 2.5 | 2.1865 |
| 1.00 | 1.2698 |
| 0.5 | 0.9899 |
| 0.1 | 0.6654 |
| 0.05 | 0.4049 |
| Vegetable Extract | Determinations No. | Absorbance | EqPir/mL |
|---|---|---|---|
| Hydroalcoholic | 1 | 1.6459 | 17.27 |
| 2 | 1.6635 | 17.56 | |
| 3 | 1.6589 | 17.48 | |
| Mean/SD | 17.44 ± 0.14 | ||
| Ultrasonicated hydroalcoholic | 1 | 1.6349 | 17.10 |
| 2 | 1.6381 | 17.15 | |
| 3 | 1.6225 | 16.90 | |
| Mean/SD | 17.05 ± 0.13 | ||
| Aqueous | 1 | 0.9236 | 5.65 |
| 2 | 0.9218 | 5.62 | |
| 3 | 0.9220 | 5.62 | |
| Mean/SD | 5.63 ± 0.01 |
| Concentration mg/mL | Absorbance at 760 nm |
|---|---|
| 5 | 3.1443 |
| 2.5 | 1.6345 |
| 1 | 0.8510 |
| 0.5 | 0.4407 |
| 0.1 | 0.1307 |
| 0.05 | 0.0768 |
| Vegetable Extract | Determinations No. | Absorbance | EqQr/mL |
|---|---|---|---|
| Hydroalcoholic | 1 | 2.3569 | 2.87 |
| 2 | 2.3411 | 2.84 | |
| 3 | 2.3779 | 2.90 | |
| Mean/SD | 2.87 ± 0.02 | ||
| Aqueous | 1 | 1.1332 | 0.9 |
| 2 | 1.0619 | 0.78 | |
| 3 | 1.1341 | 0.9 | |
| Mean/SD | 0.86 ± 0.06 |
| Vegetable Extract | White Staphylococcus | Streptococcus mitis | Streptococcus sanguis | Enterococcus faecalis | Escherichia coli |
|---|---|---|---|---|---|
| Hydroalcoholic | 18 | 26.5 | 25.5 | 11.5 | 0 |
| 20 | 26 | 26 | 12 | 0 | |
| 19 | 25.5 | 26.5 | 12.5 | 0 | |
| Ultrasonicated hydroalcoholic | 16 | 25.5 | 26.5 | 9.5 | 0 |
| 17 | 25 | 27 | 10 | 0 | |
| 16.5 | 24.5 | 27.5 | 10.5 | 0 | |
| Aqueous | Lacks antibacterial activity on all strains tested | ||||
| Polyphenol Content | Flavonoid Content | |||
|---|---|---|---|---|
| Pearson Index | p Value | Pearson Index | p Value | |
| White Staphylococcus | 0.998 | <0.01 | 0.920 | <0.01 |
| Streptococcus mitis | 0.999 | <0.01 | 0.939 | <0.01 |
| Streptococcus sanguis | 0.999 | <0.01 | 0.930 | <0.01 |
| Enterococcus faecalis | 0.999 | <0.01 | 0.924 | <0.01 |
| Escherichia coli | there is no correlation | <0.01 | there is no correlation | <0.01 |
Publisher’s Note: MDPI stays neutral with regard to jurisdictional claims in published maps and institutional affiliations. |
© 2022 by the authors. Licensee MDPI, Basel, Switzerland. This article is an open access article distributed under the terms and conditions of the Creative Commons Attribution (CC BY) license (https://creativecommons.org/licenses/by/4.0/).
Share and Cite
Șachir, E.E.; Pușcașu, C.G.; Caraiane, A.; Raftu, G.; Badea, F.C.; Mociu, M.; Albu, C.M.; Sachelarie, L.; Hurjui, L.L.; Bartok-Nicolae, C. Studies Regarding the Antibacterial Effect of Plant Extracts Obtained from Epilobium parviflorum Schreb. Appl. Sci. 2022, 12, 2751. https://doi.org/10.3390/app12052751
Șachir EE, Pușcașu CG, Caraiane A, Raftu G, Badea FC, Mociu M, Albu CM, Sachelarie L, Hurjui LL, Bartok-Nicolae C. Studies Regarding the Antibacterial Effect of Plant Extracts Obtained from Epilobium parviflorum Schreb. Applied Sciences. 2022; 12(5):2751. https://doi.org/10.3390/app12052751
Chicago/Turabian StyleȘachir, Erdogan Elvis, Cristina Gabriela Pușcașu, Aureliana Caraiane, Gheorghe Raftu, Florin Ciprian Badea, Mihaela Mociu, Claudia Maria Albu, Liliana Sachelarie, Loredana Liliana Hurjui, and Cristina Bartok-Nicolae. 2022. "Studies Regarding the Antibacterial Effect of Plant Extracts Obtained from Epilobium parviflorum Schreb" Applied Sciences 12, no. 5: 2751. https://doi.org/10.3390/app12052751
APA StyleȘachir, E. E., Pușcașu, C. G., Caraiane, A., Raftu, G., Badea, F. C., Mociu, M., Albu, C. M., Sachelarie, L., Hurjui, L. L., & Bartok-Nicolae, C. (2022). Studies Regarding the Antibacterial Effect of Plant Extracts Obtained from Epilobium parviflorum Schreb. Applied Sciences, 12(5), 2751. https://doi.org/10.3390/app12052751

